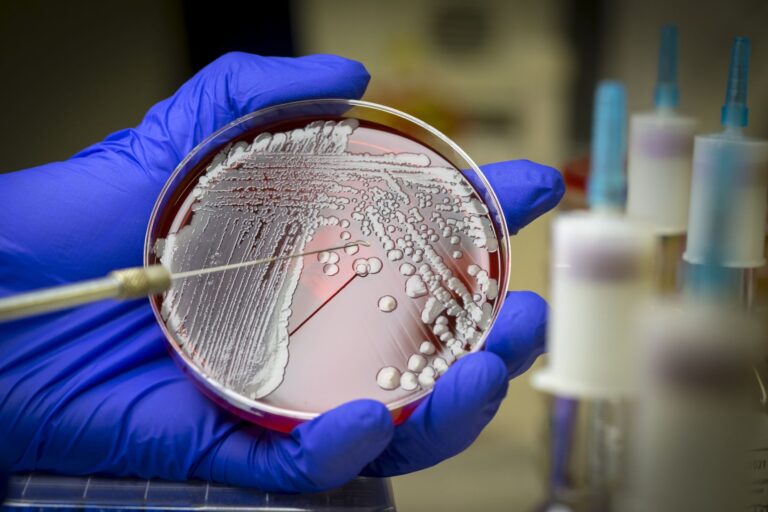
CNN Brasil

Projeto de lei sobre cigarros eletrônicos é debatido no Senado brasileiro
O Senado Federal realizou nesta terça-feira (21) uma audiência pública para debater um projeto de lei que visa regulamentar os cigarros eletrônicos no Brasil. A

O Senado Federal realizou nesta terça-feira (21) uma audiência pública para debater um projeto de lei que visa regulamentar os cigarros eletrônicos no Brasil. A

Um estudo publicado recentemente mostrou que o uso excessivo e inadequado de um tipo de bombinha para asma pode aumentar o risco de reações graves

Pesquisadores da Australian National University, na Austrália, desenvolveram uma nova ferramenta de IA (inteligência artificial) para identificar e classificar tumores cerebrais com até 95% de

Medicamentos injetáveis que tratam diabetes e obesidade aumentam o risco de um efeito colateral raro, mas grave: paralisia do estômago, de acordo com novos dados

Um estudo realizado por pesquisadores da UCSF (Universidade da Califórnia, São Francisco) mostrou que ondas de calor extremo podem causar um aumento no número de

Estudo publicado este mês na revista Emerging Infectious Diseases mostra que os vírus mayaro e chikungunya estão circulando ao mesmo tempo (cocirculação) no Estado amazônico

Um estudo realizado pela Sociedade Brasileira de Angiologia e Cirurgia Vascular (SBACV), com dados do Ministério da Saúde obtidos de janeiro de 2012 a agosto

A atriz Susana Vieira, 81 anos, revelou, durante entrevista ao Fantástico no domingo (19), que foi diagnosticada com leucemia linfocítica crônica. Durante a conversa, a
A OMS (Organização Mundial da Saúde) divulgou na sexta-feira (17) uma atualização na lista de Patógenos Bacterianos Prioritários 2024, que apresenta 15 famílias de bactérias

Pesquisadores da Oxford Population Health descobriram proteínas presentes no sangue que podem indicar risco de diferentes tipos de câncer com mais de sete anos de
FOLHA DE SALVADOR-2022 TODOS OS DIREITOS RESERVADO